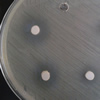
vidrios biocidas

El Centro Europeo para la Prevención y el Control de Enfermedades (ECDC) ha publicado su informe anual sobre vigilancia de la legionelosis, con datos recogidos durante 2014 en 28 países de la UE y Noruega. El número de notificaciones por millón de habitantes fue de 13.5, el más alto observado hasta ahora.
El Centro Europeo para la Prevención y el Control de Enfermedades (ECDC) ha publicado su informe anual sobre vigilancia de la legionelosis, con datos recogidos durante 2014 en 28 países de la UE y Noruega. El número de notificaciones por millón de habitantes fue de 13.5, el más alto observado hasta ahora.

 Alergias, asma, fatiga, lipoatrofia semicircular, infecciones respiratorias, e incluso cáncer de pulmón son algunas de las potenciales consecuencias de una calidad deficiente en el aire de los espacios interiores donde transcurrimos la mayor parte de nuestro tiempo. Pero ¿cuales son los principales agentes contaminantes del aire interior?
Alergias, asma, fatiga, lipoatrofia semicircular, infecciones respiratorias, e incluso cáncer de pulmón son algunas de las potenciales consecuencias de una calidad deficiente en el aire de los espacios interiores donde transcurrimos la mayor parte de nuestro tiempo. Pero ¿cuales son los principales agentes contaminantes del aire interior? Esta iniciativa responde a la necesidad de suplir la falta de armonización normativa del sector a nivel de la Unión Europea. AQUA ESPAÑA, que participó de manera destacada en el desarrollo de la norma UNE149101, entiende que este pronunciamiento es conveniente para la competitividad de las empresas españolas en el marco del acervo comunitario sobre el mercado único europeo.
Esta iniciativa responde a la necesidad de suplir la falta de armonización normativa del sector a nivel de la Unión Europea. AQUA ESPAÑA, que participó de manera destacada en el desarrollo de la norma UNE149101, entiende que este pronunciamiento es conveniente para la competitividad de las empresas españolas en el marco del acervo comunitario sobre el mercado único europeo. Investigadores de la Universidad de Lund (Suecia) han descubierto que el agua potable es purificada, en gran medida, por millones de bacterias diversas, inofensivas para los humanos, que se encuentran en tuberías de distribución y plantas de purificación del agua. Estas bacterias y otros microbios crecen en biofilms en las superficies del interior de los sistemas de distribución y tratamiento del agua.
Investigadores de la Universidad de Lund (Suecia) han descubierto que el agua potable es purificada, en gran medida, por millones de bacterias diversas, inofensivas para los humanos, que se encuentran en tuberías de distribución y plantas de purificación del agua. Estas bacterias y otros microbios crecen en biofilms en las superficies del interior de los sistemas de distribución y tratamiento del agua. El hierro es un factor esencial para muchas reacciones bioquímicas en los organismos, ya sean agentes patógenos o sus anfitriones mamíferos. Es también el caso de la bacteria Legionella pneumophila, causante de la legionelosis, que necesita un ambiente con hierro para reproducirse intracelular y extracelularmente.
El hierro es un factor esencial para muchas reacciones bioquímicas en los organismos, ya sean agentes patógenos o sus anfitriones mamíferos. Es también el caso de la bacteria Legionella pneumophila, causante de la legionelosis, que necesita un ambiente con hierro para reproducirse intracelular y extracelularmente. La Conselleria de Sanitat Universal i Salut Pública de de la Generalitat Valenciana organiza la III Jornada sobre Prevención y control de la legionelosis: nuevas perspectivas, que se celebrará en Denia (Alicante) el próximo 18 de febrero de 2016. La jornada está dirigida a profesionales del ámbito de la sanidad ambiental, a los titulares de instalaciones con riesgo de proliferación y dispersión de Legionella y a las empresas de prevención de esta bacteria.
La Conselleria de Sanitat Universal i Salut Pública de de la Generalitat Valenciana organiza la III Jornada sobre Prevención y control de la legionelosis: nuevas perspectivas, que se celebrará en Denia (Alicante) el próximo 18 de febrero de 2016. La jornada está dirigida a profesionales del ámbito de la sanidad ambiental, a los titulares de instalaciones con riesgo de proliferación y dispersión de Legionella y a las empresas de prevención de esta bacteria. Los sistemas ferroviarios subterráneos de las ciudades son indispensables para reducir la congestión del tráfico en la superficie y ofrecen a millones de pasajeros una forma rápida de transporte urbano. Sin duda, estas infraestructuras ayudan a mejorar la calidad del aire exterior que respiramos en la ciudad, pero ¿que pasa con la CAI del aire que se respira en el interior del recinto del metro?
Los sistemas ferroviarios subterráneos de las ciudades son indispensables para reducir la congestión del tráfico en la superficie y ofrecen a millones de pasajeros una forma rápida de transporte urbano. Sin duda, estas infraestructuras ayudan a mejorar la calidad del aire exterior que respiramos en la ciudad, pero ¿que pasa con la CAI del aire que se respira en el interior del recinto del metro? Científicos españoles han desarrollado vidrios con un alto contenido de óxido de zinc que presentan una excelente actividad biocida contra bacterias Gram-, Gram+ y levaduras. Estos nuevos biocidas inorgánicos no causan efectos adversos en la salud o el medioambiente y no crean problemas de resistencia antimicrobiana. Su aplicación estaría en sectores como sistemas de purificación del agua, entorno médico, envases de alimentos o productos textiles.
Científicos españoles han desarrollado vidrios con un alto contenido de óxido de zinc que presentan una excelente actividad biocida contra bacterias Gram-, Gram+ y levaduras. Estos nuevos biocidas inorgánicos no causan efectos adversos en la salud o el medioambiente y no crean problemas de resistencia antimicrobiana. Su aplicación estaría en sectores como sistemas de purificación del agua, entorno médico, envases de alimentos o productos textiles. La Universitat Jaume I de Castelló - Espaitec organiza el I Congreso Internacional de Detección rápida de Legionella 2015, que se centrará en diversos aspectos de los métodos de ensayo rápidos para prevención y evaluación de riesgo de Legionella en el agua. El evento se celebrará en Castelló el próximo 26 de noviembre.
La Universitat Jaume I de Castelló - Espaitec organiza el I Congreso Internacional de Detección rápida de Legionella 2015, que se centrará en diversos aspectos de los métodos de ensayo rápidos para prevención y evaluación de riesgo de Legionella en el agua. El evento se celebrará en Castelló el próximo 26 de noviembre. Los seres humanos liberamos al entorno aproximadamente un millón de partículas biológicas microscópicas cada hora. Dado que muchas de ellas contienen bacterias, la contribución humana en el microbioma de los entornos construidos juega probablemente un papel importante. Un estudio realizado en Oregón (EEUU) muestra que cada persona emite al ambiente una nube personal diferenciada de microbios, por la que se le puede identificar.
Los seres humanos liberamos al entorno aproximadamente un millón de partículas biológicas microscópicas cada hora. Dado que muchas de ellas contienen bacterias, la contribución humana en el microbioma de los entornos construidos juega probablemente un papel importante. Un estudio realizado en Oregón (EEUU) muestra que cada persona emite al ambiente una nube personal diferenciada de microbios, por la que se le puede identificar.